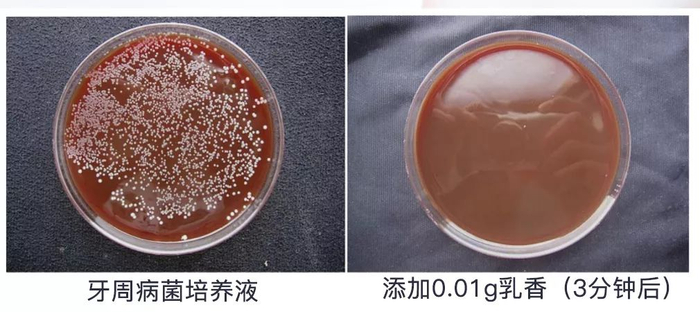

前两天一个同事突发胃病住院,做了呼吸监测才发现胃病的罪魁祸首原来是幽门螺杆菌。

这种疾病的初期表现为胃部反酸,平时喉咙总有一种烧心的灼热感,上腹部隐隐作痛。
一旦发展成胃溃疡,就会感觉胃随时随地都被几万根针在扎,就算吃饭喝水都无法缓解疼痛,每天都有痛不欲生的感觉。

你以为没有表现出上述症状就和自己无关了,去年《人民日报》的微博发过一则可怕的报道:
我国有超过7亿人口都感染了幽门螺杆菌!
你可能早就被感染或者是潜在的感染对象了!

幽门螺杆菌的传播途径大致分为以下几种:聚餐不用公筷,跟女朋友接吻,便后不洗手吃东西。简直是生活处处都是陷阱啊!

怎么防治?既然科学生命幽门螺杆菌是通过口腔进入人体的。那就把他们全部消灭在口腔里,不就可以杜绝胃病的发生了嘛!
为了解决这个问题,韩国的专家们研究出了这一款牙膏,每天只需刷牙3分钟,就可以对抗口腔中幽门螺杆菌!
它就是麦斯特凯斯乳香牙膏

韩国专利厅认证,斩获国际大奖
麦斯特凯斯乳香牙膏来自韩国,自诞生以来就各种国际大奖拿到手软。它在2008年的时候参加首尔国际发明展会:从34个国家486个展品中脱颖而出并且荣获银奖。

而且还因此获得了韩国专利厅的专利认证,作为牙膏中重要的原料的「乳香」也得到原产地名称的认证。

乳香有效对抗口腔中的幽门菌
获奖无数的重要原因是:它是第一款添加乳香的牙膏!

乳香,又称“希俄斯之泪”,是从乳香黄连木中采取的树胶提取物。爱琴海希俄斯岛南部的黄连木,在割开树皮时会流出乳香脂。

它珍贵,其生产受到岛上数个中世纪延续至今的村庄所控制,产出的数量十分的稀少。

希腊人从5000年前就发现了乳香有益于健康,他们将乳香进行焚烧或直接食用。乳香也是诸多昂贵料理的调味料之一,其价值等同于黄金。

这样珍贵的乳香具有天然抑菌的功能,大家都知道蜂胶的杀菌作用很强,乳香的杀菌力竟然是蜂胶的15.6倍!
刷牙3分钟,对抗口腔中的幽门菌
抑菌实验显示,把0.01g乳香添加到胃癌发病菌-幽门螺杆菌的培养液里,在3分钟内就可以达到100%的抑制率!

那牙膏中的乳香含量能否达到抑菌的浓度呢?
我们称量了一下,刷一次牙需要0.5g左右的牙膏。

120g麦斯特凯斯乳香牙膏中含有2%的乳香,120g*2%=2.4g
就是说每0.5g牙膏中刚刚好含有(0.5*2.4)/120=0.01g 的乳香
因此每天只要坚持刷3分钟,就可以达到试验中抑菌的效果了!

权威检测报告了解一下~👆👆👆
全美国十大癌症专家强烈推荐
它在学术界的认可度也很高:身为全美十大癌症专家的美国纽约洛克菲勒大学的巴巴拉博士,强烈推荐乳香,作为代替抗生素治疗癌症。

日本静冈县立大学也在其学术报告中证实了乳香对抗胃溃疡有奇效,其治愈率达到了80%。

本照片是在幽门螺旋杆菌里添加乳香(200ppm)30分钟后,用显微镜拍摄的幽门螺旋杆菌的状况。照片里清晰地看到因细胞膜的破坏,细菌在被灭绝。
降低幽门螺杆菌复发率
那已经感染上幽门螺杆菌的人群怎么办?使用这款牙膏还有效果吗?
果小妹去查询了相关的文献:

文献表明,幽门螺杆菌之所以反反复复,不是因为四联疗法没有杀死胃中的HP。
而是他们忽视了口腔的清洁,才导致隐藏在牙菌斑里的HP再一次偷偷溜回胃里!
四联疗法+乳香牙膏
超强抑制幽门菌!
因此治疗幽门螺杆菌最好的方式就是四联疗法加上乳香牙膏,才能消灭你身体里的幽门螺杆菌!

清除牙菌斑,口气更清新
牙菌斑清除率高

评价一款牙膏的好坏,最基本的要求就是它对牙菌斑的清除率。
在牙齿模型上涂满了黏糊糊的颜料模拟牙菌斑的生长情况,并且用乳香牙膏对局部进行清洁。

在认真的刷刷刷之后,牙齿模型焕然一新!
实验数据也显示,乳香牙膏对牙周病菌群的抑制效果也超级棒!
▲把稀释乳香1ɡ的1%添加到牙菌培养液中
淡淡中药味 清新不刺激
极果君是一个口腔非常敏感的人,他测试了某露洁和乳香牙膏(太可怜了...)

▲某露洁牙膏
某露洁因为添加了沁凉薄荷,所以感觉感觉薄荷的辛辣味迟迟无法散去。

▲乳香牙膏
不过他对乳香牙膏的评价相当好:里面应该没有添加任何的刺激性成分,对口腔很友好,有一点淡淡的中药味,用完之后感觉非常舒服。
清新口气 改善胀气打嗝
很多人都有口臭,原因大概分为三类:
1.食物残渣发酵产生腐败的味道
2.口腔中有炎症(牙周炎,牙龈炎)
3.胃部感染了幽门螺杆菌,胃气上行,难闻的气味就会伴随着打嗝喷涌而出

麦斯特凯斯牙膏强大的抑菌力可以消灭口腔中的有害菌群,再加上对幽门螺杆菌的抑制作用,双管齐下,还你由内到外的清新口气!
泡沫丰富,刷牙更干净
通常来说一款牙膏的泡沫越丰富,跟口腔的接触面积会更大,可以看到麦斯特凯斯牙膏的泡沫丰富度不错,可以满足基本的清洁需求。

单手开盖设计,防止二次感染
果小妹有一个毛病,喜欢挤上牙膏后在家里走来走去,直到需要漱口的时候才会回到卫生间。

这就导致了我会经常找不到我的牙膏盖,然后上面就会开始繁殖密密麻麻的细菌,麦斯特凯斯牙膏的单手开盖设计就杜绝了这种烦恼。

添加HAP粒子,修补牙齿釉质层
麦斯特凯斯乳香牙膏中还加入了与牙齿相同的成分,即羟基磷灰石(HAP)粒子。HAP粒子与牙釉质有着良好的生物亲和性。

在去除牙渍的同时,可以修补牙齿表面缺失的釉质层,并且在牙齿表面自然形成一层保护层,让牙齿更加强健!
好评如潮!
这款牙膏自从上市以来就收获了无数用户的好评。
很多人坚持使用之后都感觉口气清新了很多,牙龈出血的情况也有所改善~
而且一人得病全家治疗,给家人购买也是正确的选择哦!

刷牙3分钟
有效对抗口腔中的幽门螺杆菌哦
抗幽门螺旋杆菌 去口臭留香
韩国进口麦斯特凯斯乳香牙膏
原价每支138元,今日特价99元包邮
戳图购买
▼▼▼
【本文来自微信公众号“跑步指南”】

